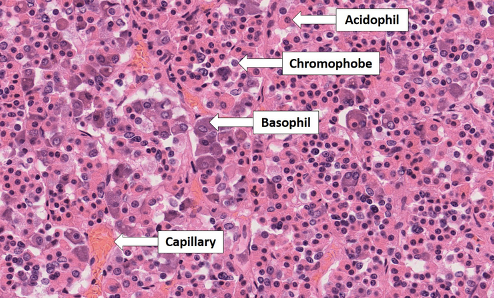

what do neural cells do
communicate with each other and with cells of sensory and effector tissues by means of neurons
where does the adenohypophysis (anterior pituitary) arise from
rathke’s pouch
what controls the pituitary
hypothalamus
what are the 6 hormones produced by the anterior pituitary
TSH
ACTH
LH
FSH
HGH (human growth hormone)
prolactin
what are the two hormones produced by the posterior pituitary
oxytocin
vasopressin (ADH)
which hormone inhibits growth hormone
somatostatin
which hormone inhibits prolactin
dopamine
what are the three main cell types of the adenohypophysis (anterior pituitary)
chromophobic
eosinophilic (acidophilic)
basophilic
what are lactotrophs and what do they secrete
anterior pituitary acidophilic cells that secrete prolactin
what are somatotrophs and what do they secrete
anterior pituitary acidophilic cells that secrete growth hormone or somatotrophin
what are corticotrophs and what do they produce
anterior pituitary basophilic cells that produce pro-opiomelanocortin (POMC) which becomes ACTH
what are thyrotrophs and what do they produce
anterior pituitary basophilic cells that produce TSH
what are gonadotrophs and what do they produce
anterior pituitary basophilic cells that produce gonadotropins
what is the most common cause of hyperpituitarism
anterior pituitary adenoma
what are the most common causes of hypopituitarism
ischemic injury, surgery, radiation, or inflammation
what are the 5 classifications of pituitary adenomas
hormone production
functional vs non-functional
cell type
sporadic vs inherited
size
what is a functional adenoma
one that produces excess hormone production that causes clinical manifestations
what is a non-functional adenoma
one that does not produce thyroid hormones - no clinical manifestations
how big is a microadenoma
less than 1 cm
how big is a macroadenoma
greater than 1 cm
what two things do atypical pituitary adenomas have
a TP53 mutation and brisk mitotic activity
what is the other name for a prolactinoma
lactotroph adenoma
which pituitary lesion has a cap-like “Golgi-pattern”
prolactinoma (lactotroph adenoma)

what is the most common hyperfunctioning pituitary adenoma
prolactinoma (lactotroph adenoma)


































